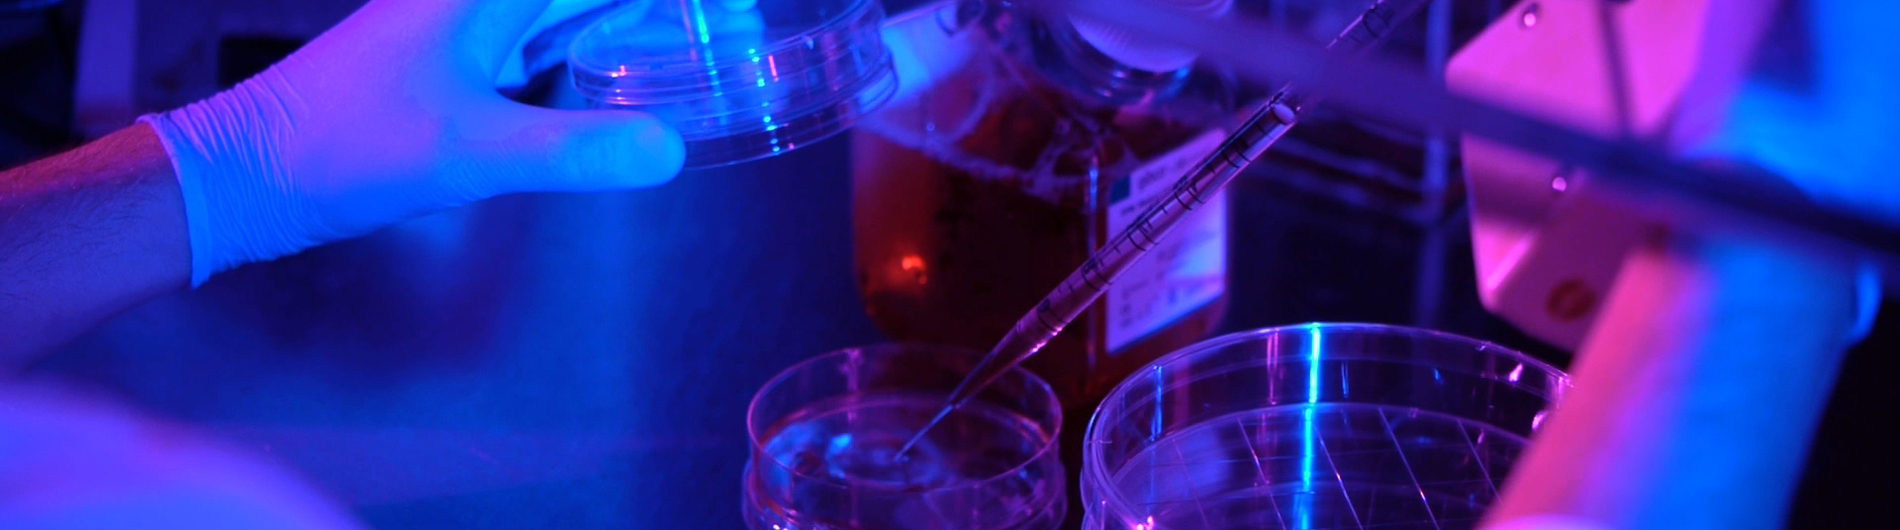

Welcome to the Center for RNA Biology: From Genome to Therapeutics
The Center for RNA Biology: From Genome to Therapeutics provides a means of conducting interdisciplinary research into the function, structure, and processing of RNA. Members of the center are drawn from the faculty of seven departments at the University from both the College (Arts & Sciences and Engineering) and the School of Medicine and Dentistry. The Center supports collaborative research programs, sponsors seminars, and maintains equipment for collaborative research. Plans are underway to expand the member faculty with key hires in areas of interest in the Medical Center strategic plan.
The RNA Center houses a Typhoon FLA 9500 biomolecular imager from GE Healthcare Life Sciences, and QuantStudio 5 Real-Time PCR System and Step One Plus PCR thermal cyclers from Applied Biosystems. The main instrumentation contact is Dr. Scott Butler.
People
The Center for RNA Biology is composed of research groups from departments across the University of Rochester.
Collaborative Research
The collegial environment at the University of Rochester fosters collaborative research.
Seminars
The University of Rochester Medical Center community hosts preeminent seminar speakers in RNA Biology.
Leadership
Leadership
NIH T32 Sponsored Programs
- NIH T32 Training Grant in Cellular, Biochemical & Molecular Sciences
- Graduates Working in Science (GWIS)
Social Media
Social Media
Upcoming Events
There is no upcoming seminar scheduled.
Latest News
August 25, 2025
Fragile X Syndrome: What Happens in the Brain?
June 16, 2025
Studies on mRNA show it could potentially be used to cure HIV
April 23, 2025
RNA Discoveries Leading to Cutting-Edge Cures
March 27, 2025
RNA and Cancer Scientist Eric Wagner Receives Lifetime Honor
March 27, 2025
Neuroscience & RNA Biology: How mRNA Decay Shapes Health & Disease